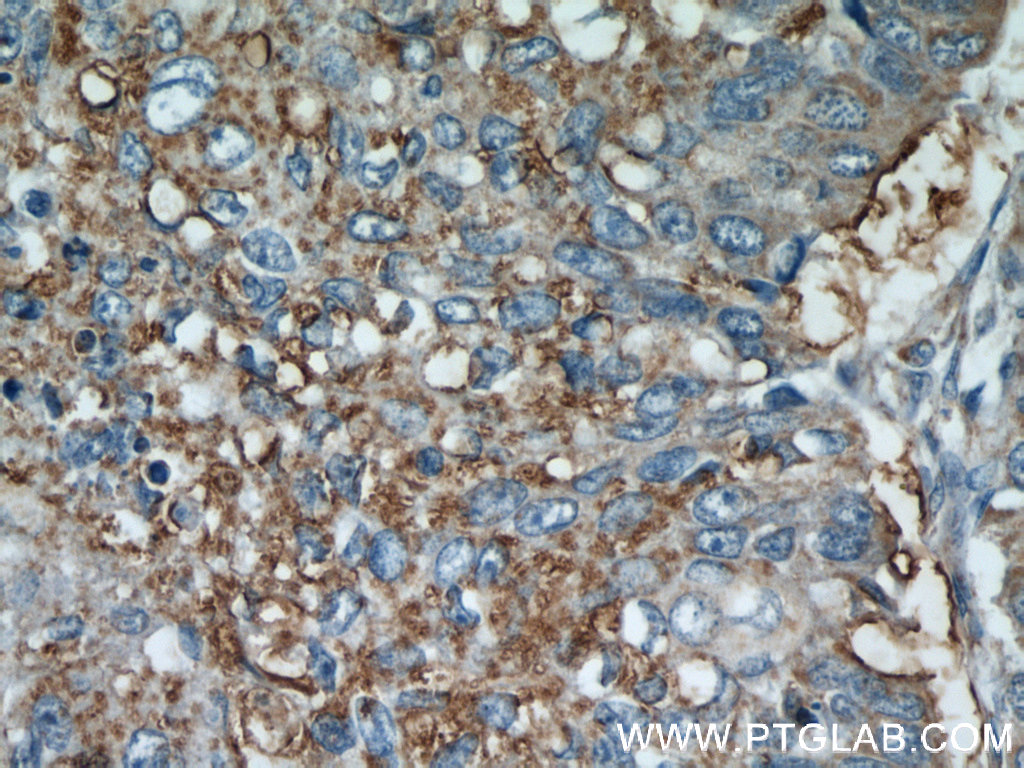

验证数据展示
经过测试的应用
| Positive WB detected in | mouse thymus tissue, HeLa cells |
| Positive IP detected in | HeLa cells |
| Positive IHC detected in | human lung cancer tissue, human tonsillitis tissue Note: suggested antigen retrieval with TE buffer pH 9.0; (*) Alternatively, antigen retrieval may be performed with citrate buffer pH 6.0 |
| Positive IF/ICC detected in | HeLa cells |
推荐稀释比
| 应用 | 推荐稀释比 |
|---|---|
| Western Blot (WB) | WB : 1:500-1:2000 |
| Immunoprecipitation (IP) | IP : 0.5-4.0 ug for 1.0-3.0 mg of total protein lysate |
| Immunohistochemistry (IHC) | IHC : 1:50-1:500 |
| Immunofluorescence (IF)/ICC | IF/ICC : 1:200-1:800 |
| It is recommended that this reagent should be titrated in each testing system to obtain optimal results. | |
| Sample-dependent, Check data in validation data gallery. | |
发表文章中的应用
| WB | See 5 publications below |
产品信息
11162-1-AP targets EIF2S3 in WB, IHC, IF/ICC, IP, ELISA applications and shows reactivity with human, mouse samples.
| 经测试应用 | WB, IHC, IF/ICC, IP, ELISA Application Description |
| 文献引用应用 | WB |
| 经测试反应性 | human, mouse |
| 文献引用反应性 | human |
| 免疫原 |
CatNo: Ag1650 Product name: Recombinant human EIF2S3 protein Source: e coli.-derived, PGEX-4T Tag: GST Domain: 173-472 aa of BC019906 Sequence: HLAAIEIMKLKHILILQNKIDLVKESQAKEQYEQILAFVQGTVAEGAPIIPISAQLKYNIEVVCEYIVKKIPVPPRDFTSEPRLIVIRSFDVNKPGCEVDDLKGGVAGGSILKGVLKVGQEIEVRPGIVSKDSEGKLMCKPIFSKIVSLFAEHNDLQYAAPGGLIGVGTKIDPTLCRADRMVGQVLGAVGALPEIFTELEISYFLLRRLLGVRTEGDKKAAKVQKLSKNEVLMVNIGSLSTGGRVSAVKADLGKIVLTNPVCTEVGEKIALSRRVEKHWRLIGWGQIRRGVTIKPTVDDD 种属同源性预测 |
| 宿主/亚型 | Rabbit / IgG |
| 抗体类别 | Polyclonal |
| 产品类型 | Antibody |
| 全称 | eukaryotic translation initiation factor 2, subunit 3 gamma, 52kDa |
| 别名 | EIF2G, EIF2, eIF 2gX, eIF 2gA, eIF 2 gamma X |
| 计算分子量 | 52 kDa |
| 观测分子量 | 52 kDa |
| GenBank蛋白编号 | BC019906 |
| 基因名称 | EIF2S3 |
| Gene ID (NCBI) | 1968 |
| RRID | AB_2246331 |
| 偶联类型 | Unconjugated |
| 形式 | Liquid |
| 纯化方式 | Antigen affinity purification |
| UNIPROT ID | P41091 |
| 储存缓冲液 | PBS with 0.02% sodium azide and 50% glycerol, pH 7.3. |
| 储存条件 | Store at -20°C. Stable for one year after shipment. Aliquoting is unnecessary for -20oC storage. |
背景介绍
Interacts with GTP and initiator methionyl-tRNA, translation initiation factor eIF2 forms a ternary complex that binds the 40S ribosome and then scans an mRNA to select the AUG start codon for protein synthesis[PMID: 9736774]. Junction of the 60S ribosomal subunit to form the 80S initiation complex is preceded by hydrolysis of the GTP bound to eIF-2 and release of an eIF-2-GDP binary complex. In order for eIF-2 to recycle and catalyze another round of initiation, the GDP bound to eIF-2 must exchange with GTP by way of a reaction catalyzed by eIF-2B. EIF2S3 is the core subunit of the heterotrimeric eIF2 complex.[PMID:23063529]
实验方案
| Product Specific Protocols | |
|---|---|
| IF protocol for EIF2S3 antibody 11162-1-AP | Download protocol |
| IHC protocol for EIF2S3 antibody 11162-1-AP | Download protocol |
| IP protocol for EIF2S3 antibody 11162-1-AP | Download protocol |
| WB protocol for EIF2S3 antibody 11162-1-AP | Download protocol |
| Standard Protocols | |
|---|---|
| Click here to view our Standard Protocols |
发表文章
| Species | Application | Title |
|---|---|---|
Nat Cell Biol O-GlcNAcylation determines the translational regulation and phase separation of YTHDF proteins | ||
Nat Neurosci Deletion of TOP3β, a component of FMRP-containing mRNPs, contributes to neurodevelopmental disorders. | ||
Front Biosci (Landmark Ed) EIF2Ss, a Novel c-Myc-Correlated Gene Family, is Associated with Poor Prognosis and Immune Infiltration in Pancreatic Adenocarcinoma | ||
Mol Biol Cell PRMT7 Methylates Eukaryotic Translation Initiation Factor 2α and Regulates its Role in Stress Granule Formation. |